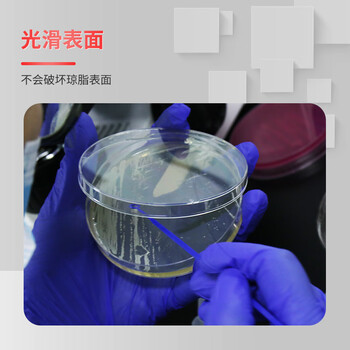
世泰 接种环一次性无菌塑料微生物采样棒接种棒丝接种针涂布棒实验室用耗材 【10μL无菌接种环】20支

| 环直径 | 5mm |
| 总长 | 200mm |
供应商价:供应商价为商品的销售价,是您最终决定是否购买商品的依据。
划线价:商品展示的划横线价格为参考价,并非原价,该价格可能是品牌专柜标价、商品吊牌价或由品牌供应商提供的正品零售价(如厂商指导价、建议零售价等)或该商品在供应商平台上曾经展示过的销售价;由于地区、时间的差异性和市场行情波动,品牌专柜标价、商品吊牌价等可能会与您购物时展示的不一致,该价格仅供您参考。
折扣:如无特殊说明,折扣指销售商在原价、或划线价(如品牌专柜标价、商品吊牌价、厂商指导价、厂商建议零售价)等某一价格基础上计算出的优惠比例或优惠金额;如有疑问,您可在购买前联系销售商进行咨询。
异常问题:商品促销信息以商品详情页“促销”栏中的信息为准;商品的具体售价以订单结算页价格为准;如您发现活动商品售价或促销信息有异常,建议购买前先联系销售商咨询。